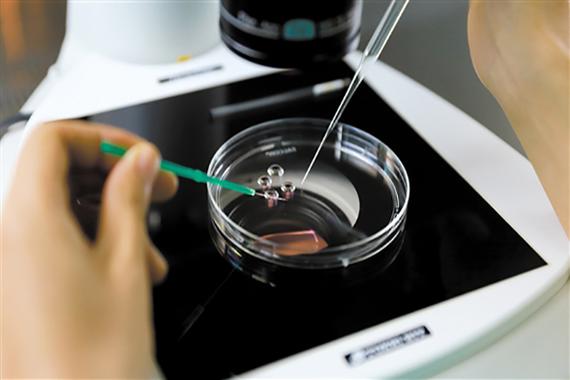
广州三代供卵试管儿子【广州三代供卵试管儿子的成长故事】

在广州,有一对夫妇通过三代供卵试管技术成功诞下了一个健康的儿子。这个儿子的成长故事充满了感人的细节和挑战,让人们对于生命和科技的力量有了更深刻的认识。
1. 试管婴儿的诞生
这个儿子是通过三代供卵试管技术诞生的。这项技术是指利用三代女性的卵子,分别来自祖母、母亲和孩子的卵子,结合父亲的精子,通过试管婴儿技术来进行受精和胚胎移植。这种技术的成功让这个家庭的梦想成真,也为其他不孕不育家庭带来了希望。
2. 成长中的挑战
尽管这个儿子来自于科技的奇迹,但在成长过程中也面临着许多挑战。他需要面对来自社会的好奇和误解,需要承受压力和挑战。父母为了保护他,不得不面对各种困难和挑战,这也让他们更加坚定地支持和爱护自己的孩子。
3. 家庭的支持
在这个儿子的成长故事中,家庭的支持起到了至关重要的作用。父母不仅提供了物质上的支持,更重要的是他们给予了孩子足够的爱和关怀,让他在成长过程中感受到家庭的温暖和安全感。而祖母的卵子也成为了他与家庭联系的纽带,让他感受到家族的温暖和传承。
4. 未来的展望
这个儿子的成长故事充满了感动和鼓舞,他的出生不仅给了家庭希望,也为社会带来了对于生命和科技的思考。未来,他将面临更多的挑战和机遇,但他所拥有的坚强和爱将成为他前行的动力,也将继续为更多人带来希望和鼓舞。
相关问答:
Q: 三代供卵试管技术有哪些优势和挑战?
A: 这项技术可以帮助一些不孕不育家庭实现生育梦想,但也面临着伦理和道德等方面的挑战。
Q: 这个儿子的成长故事给我们带来了什么启示?
A: 他的成长故事告诉我们,爱和支持是孩子成长中最重要的因素,也让我们思考生命和科技的关系。






